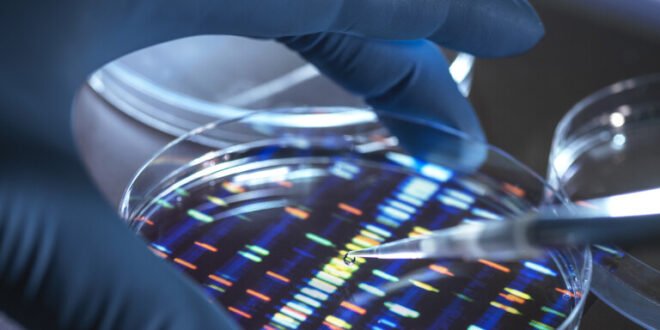

منبر العراق الحر :
قال فريق من العلماء إنه حدد شكلا وراثيا جديدا لمرض ألزهايمر، يؤكد الحاجة الملحة لتطوير استراتيجيات العلاج والوقاية المتخصصة.
ووجد الفريق من الولايات المتحدة أن جميع الأفراد تقريبا الذين يحملون نسختين من متغير الجين APOE4، المعروفة باسم متماثلات الزيغوت APOE4، من المحتمل أن تظهر عليهم علامات الحالة العصبية في وقت أبكر من أولئك الذين لديهم متغيرات أخرى من جين APOE.
ويشير مصطلح متماثلات الزيغوت، أو الاقترانية الزيغوتية إلى الدرجة التي تشترك فيها نسختان من الجين بنفس التسلسل الجيني، بمعنى آخر، تمثل درجة تشابه الأليلات (نسخة أو شكل بديل للجين) في الكائن الحي.
ويعتقد العلماء الآن أن 95% من الذين تزيد أعمارهم عن 65 عاما ويحملون نسختين من APOE4 تظهر عليهم علامات مبكرة للمرض، ما يجعله شكلا وراثيا متميزا لألزهايمر.
وتشير النتائج إلى أنه بالنسبة للأشخاص الذين يحملون نسختين من الجين، فإن APOE4 ليس مجرد عامل خطر، بل إنه سبب أساسي للمرض الذي يسرق العقل.
ويمكن أن تبدأ الأعراض قبل سبع إلى عشر سنوات من ظهورها لدى كبار السن الآخرين الذين يصابون بمرض ألزهايمر. وهذا يستدعي تطوير استراتيجيات بحثية متخصصة وأساليب علاجية وتجارب سريرية لهؤلاء الأشخاص، وفقا للعلماء.
وتستند النتائج التي نشرت في مجلة Nature Medicine، إلى بيانات سريرية من أكثر من 10 آلاف شخص، بالإضافة إلى بيانات مرضية من أكثر من 3000 متبرع بالدماغ.
وقال الدكتور خوان فورتيا، مدير منطقة الأبحاث المتعلقة بالأمراض العصبية وعلم الأعصاب والصحة العقلية في معهد أبحاث سانت باو في برشلونة بإسبانيا: “تمثل هذه البيانات إعادة تصور للمرض أو ما يعنيه أن يكون متماثل الزيغوت بالنسبة للجين APOE4″.
وهذا الجين معروف منذ أكثر من 30 عاما بارتباطه بزيادة خطر الإصابة بمرض ألزهايمر، لكننا نعلم الآن أن جميع الأفراد الذين لديهم هذا الجين المكرر يصابون بمرض ألزهايمر، وهذا أمر مهم لأنهم يمثلون ما بين 2 و 3% من السكان”.
ومن المعروف أن الطفرات في ثلاثة جينات، APP وPSEN1 وPSEN2، تسبب شكلا نادرا من مرض ألزهايمر معروف باسم ADAD (مرض ألزهايمر المبكر السائد جسديا). وهذا النوع من المرض ينتشر وراثيا.
ويعد الجين APOE واحدا من العديد من الجينات الأخرى المرتبطة بألزهايمر ويأتي في ثلاثة أشكال مختلفة: APOE2، وAPOE3، وAPOE4. ويحمل كل شخص نسختين من APOE، واحدة موروثة من كل من الوالدين.
وقد أظهرت الدراسات السابقة أن وجود متغير واحد على الأقل من جين APOE4، يضاعف خطر الإصابة بالمرض ثلاث مرات تقريبا، في حين أن وجود نسختين منه يزيد من خطر الإصابة بما يصل إلى اثني عشر ضعفا.
وفي الدراسة الحديثة، وجد الفريق أن غالبية الذين لديهم نسختين من APOE4 أظهروا علامات المرض عند سن 55 عاما، مقارنة بأولئك الذين لديهم متغير جيني آخر، مثل APOE3.
وبحلول عمر 65 عاما، كان لدى جميعهم تقريبا (95%) مستويات غير طبيعية من البروتين المعروف باسم الأميلويد في السائل الذي يحيط بالدماغ والحبل الشوكي، وهي علامة رئيسية لمرض ألزهايمر. وكان 75% منهم لديهم فحوصات أميلويد إيجابية في الدماغ.
وبناء على هذه النتائج، يقترح العلماء أن المتغير الجيني لجين APOE4 ليس فقط عامل خطر لمرض ألزهايمر، كما كان يعتقد سابقا، ولكنه يمكن أن يمثل أيضا شكلا وراثيا متميزا لمرض ألزهايمر.
المصدر: إندبندنت
 منبر العراق الحر منبر العراق الحر
منبر العراق الحر منبر العراق الحر